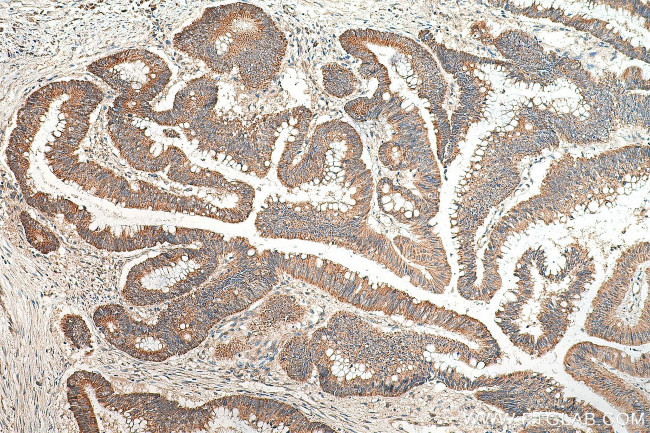
INO80 Antibody in Immunohistochemistry (Paraffin) (IHC (P))
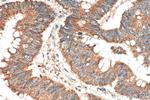
INO80 Antibody in Immunohistochemistry (Paraffin) (IHC (P))

Search
Proteintech
INO80 Polyclonal Antibody
{{$productOrderCtrl.translations['antibody.pdp.commerceCard.promotion.promotions']}}
{{$productOrderCtrl.translations['antibody.pdp.commerceCard.promotion.viewpromo']}}
{{$productOrderCtrl.translations['antibody.pdp.commerceCard.promotion.promocode']}}: {{promo.promoCode}} {{promo.promoTitle}} {{promo.promoDescription}}. {{$productOrderCtrl.translations['antibody.pdp.commerceCard.promotion.learnmore']}}
产品信息
18810-1-AP
种属反应
已发表种属
宿主/亚型
分类
类型
抗原
偶联物
形式
浓度
规格
纯化类型
保存液
内含物
保存条件
运输条件
靶标信息
DNA helicase and probable main scaffold component of the chromatin remodeling INO80 complex which is involved in transcriptional regulation, DNA replication and probably DNA repair; according to PubMed:20687897 the contribution to DNA double-strand break repair appears to be largely indirect through transcriptional regulation. Recruited by YY1 to YY1-activated genes, where it acts as an essential coactivator. Binds DNA. In vitro, has double-stranded DNA-dependent ATPase activity. Involved in UV-damage excision repair, DNA replication and chromosome segregation during normal cell division cycle.
仅用于科研。不用于诊断过程。未经明确授权不得转售。
生物信息学
蛋白别名: Chromatin-remodeling ATPase INO80; DNA helicase INO80; DNA helicase-related INO80 complex homolog 1; DNA helicase-related protein INO80; hINO80; homolog of yeast INO80; INO80 complex homolog 1; INO80 complex subunit A; INO80 homolog; putative DNA helicase INO80 complex homolog 1; unnamed protein product; yeast INO80-like protein
基因别名: 2310079N15Rik; 4632409L19Rik; INO80; INO80A; INOC1; KIAA1259; RGD1310969
UniProt ID: (Human) Q9ULG1, (Mouse) Q6ZPV2
Entrez Gene ID: (Human) 54617, (Mouse) 68142, (Rat) 296084